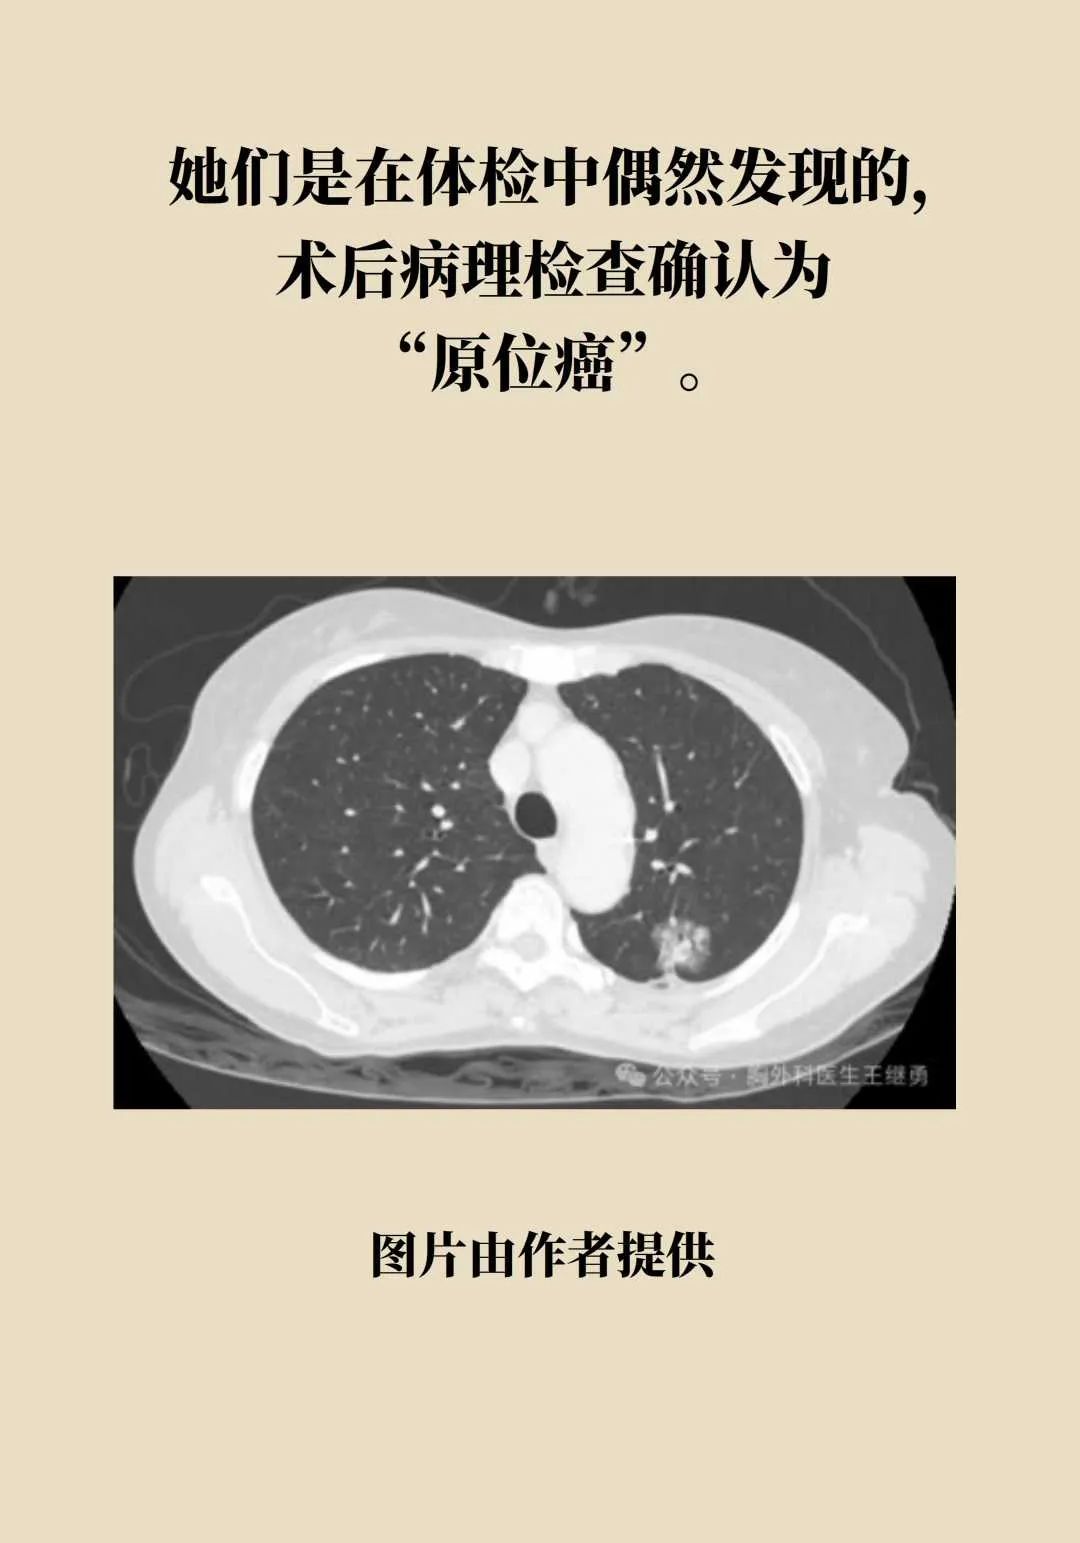

4台肺癌手术,2名“90后”患者,这届年轻人的肺怎么了?
原创 喵大夫 猫大夫医学科普

专 家 简 介
王继勇,广州中医药大学第一附属医院胸心外科主任,博士,硕士生导师。
现为中国医师协会中西医结合胸心外科专委会副主任委员,广东省医学会胸外科分会副主任委员,广东省医师协会胸外科分会副会长,广东省中西医结合心胸外科分会副主任委员,广州抗癌协会呼吸介入分会副主任委主员,中国医师协会手汗症专业组委员,广东省中医外科学会副主委,中国医师协会重症肌无力联盟专家,广东省创伤学会胸外科组副组长,广东省医疗行业协会胸外科分会常务委员。第二届羊城好医生,2016年度广州好人。
原标题:《4台肺癌手术,2名90后患者!这届年轻人的肺怎么了?》
阅读原文